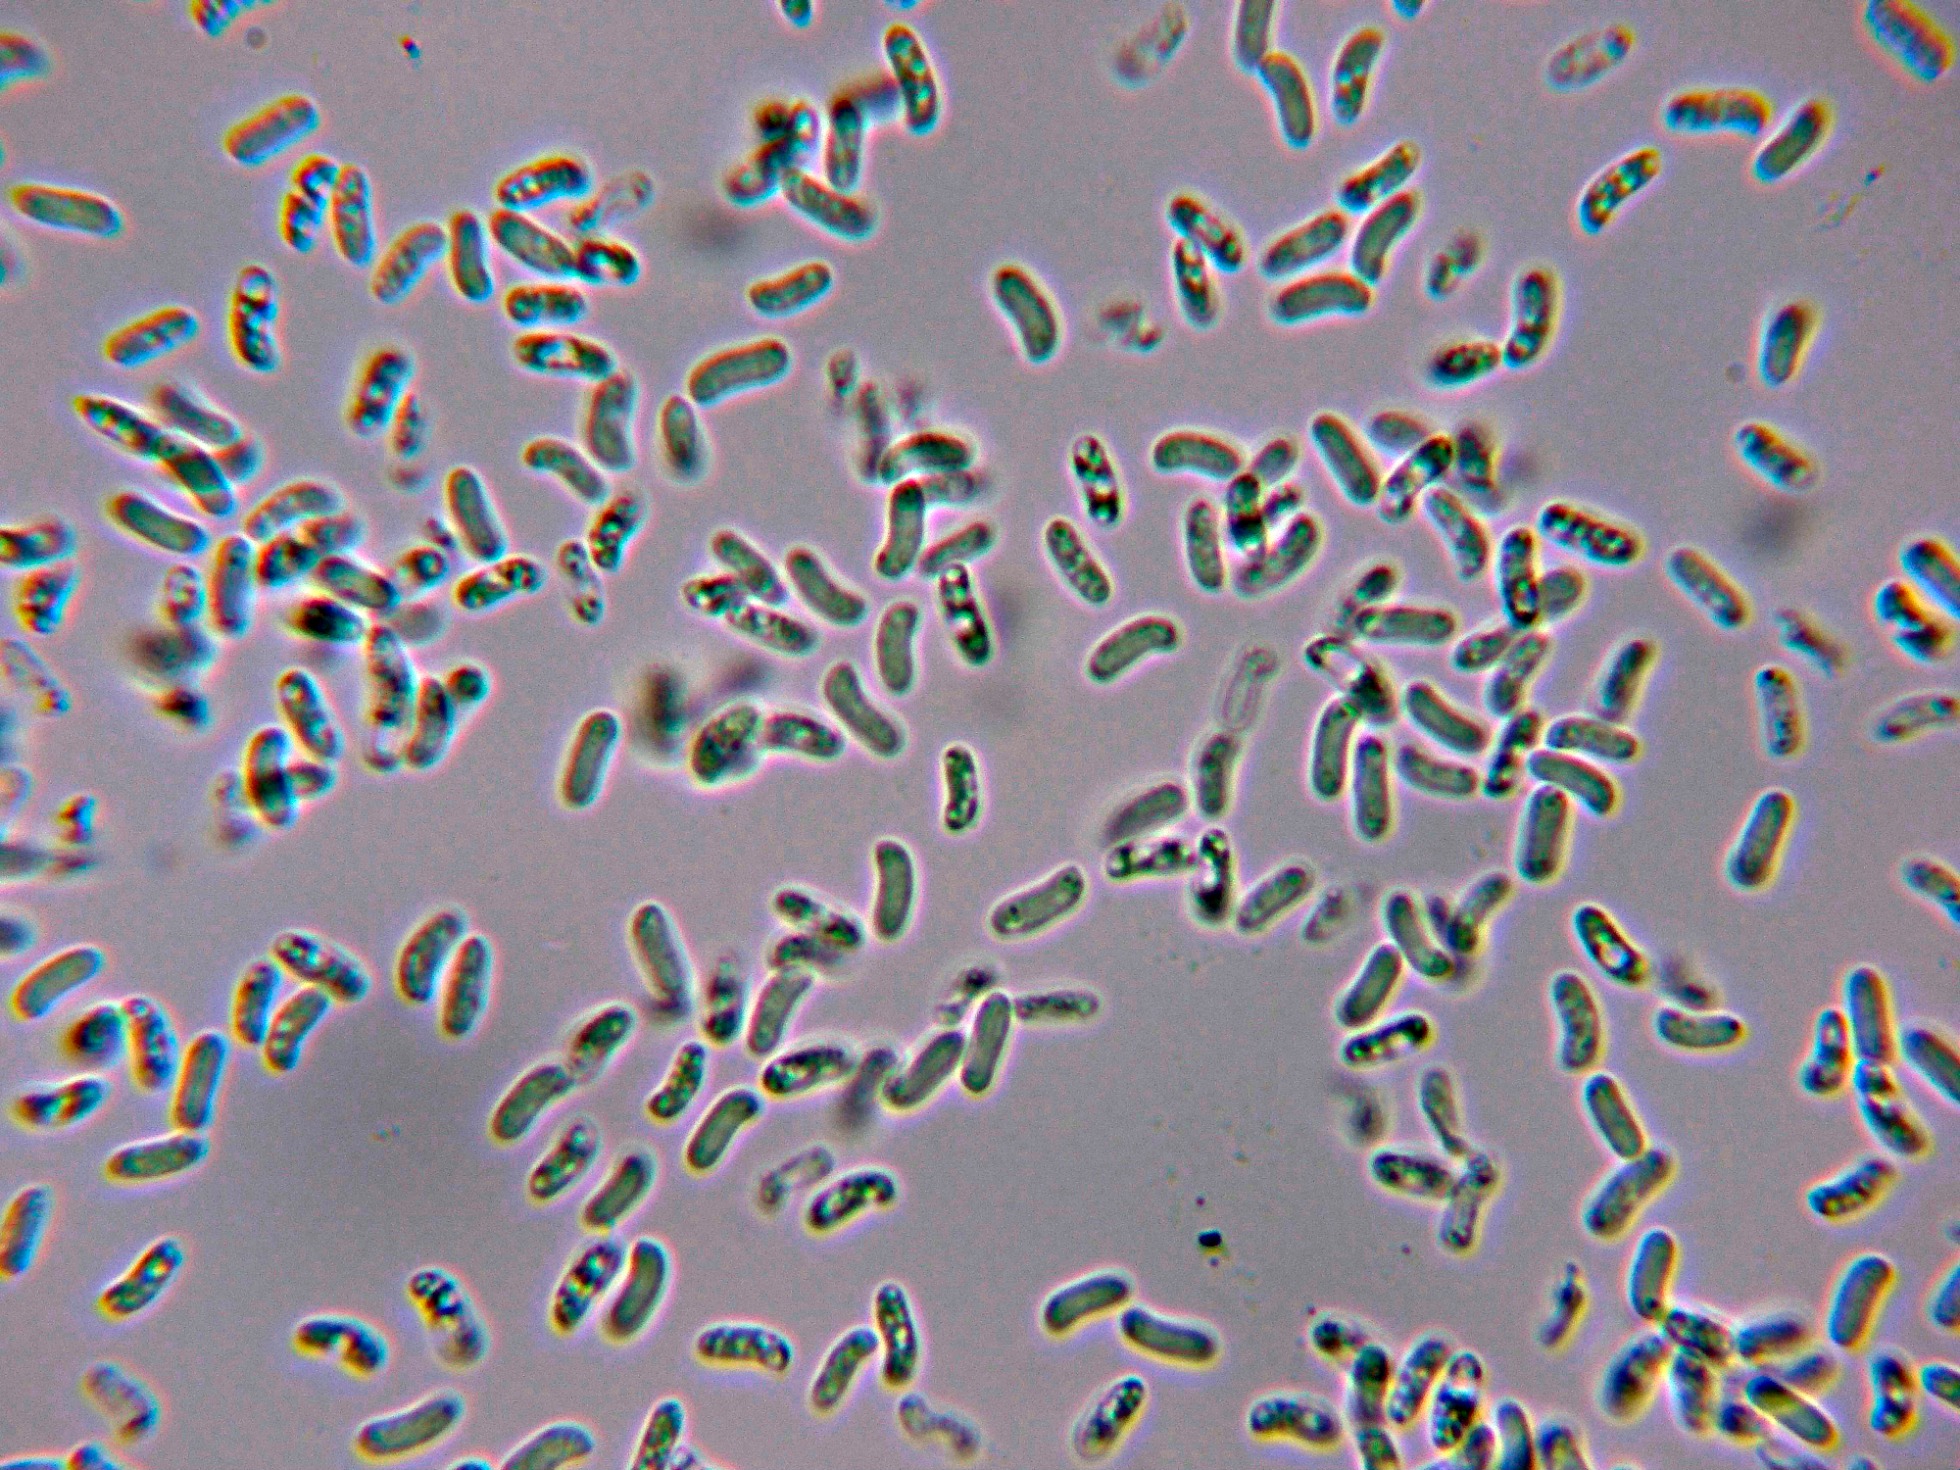

- Foro
- Foros sobre Micología de fungipedia
- Microscopía
- Trametopsis cervina (Schwein.) Tomšovský. Microscopía.
 Trametopsis cervina (Schwein.) Tomšovský. Microscopía.
Trametopsis cervina (Schwein.) Tomšovský. Microscopía.
- Josep Torres
-
 Autor del tema
Autor del tema
- Fuera de línea
- Moderador
-

Menos
Más
- Mensajes: 8746
- Gracias recibidas: 8379
3 años 1 mes antes - 3 años 1 mes antes #108688
por Josep Torres
Hola a tod@s.
Un Polyporal quer solo recuerdo haberlo visto una vez allá por 2014, cuando ni tan siquiera había empezado con la microscopía, después de casi 10 años por fin me lo he vuelto a encontrar y he podido confirmar la especie.
Trametopsis cervina (Schwein.) Tomšovský
En el punto de recogida de muestras los ejemplares ya no presentaban ni mucho menos su mejor aspecto, con una consistencia muy parecida a la de la madera, llegué a considerar la posibilidad de que quizás estuvieran ya muertos.
Ya en casa y después de sumergirlos en agua durante un par de horas su aspecto ya cambió considerablemente, con una consistencia bastante blanda y flexible.
Detalle del himenio, con aspecto daedaleoide.
Al depositar el ejemplar sobre la mesa boca abajo, a las dos horas ya había soltado una buena cantidad de esporas, la esporada en masa de color blanco.
Con sistema hifal dimítico, con las hifas generativas provistas de fíbulas,
Las hifas subhimeniales:
Las hifas de la superficie del sombrero (cutícula)
Sin cistidios observados, aunque en la literatura se citan unos pequeños cistidiolos fusoides muy escasos y dispersos.
Los basidios:
Detalle de la base fibulada de los basidios:
Las esporas en solución de Rojo Congo diluido.
Las esporas en agua.
Estas esporas obtenidas por esporulación natural y en agua del grifo con unas medidas de:
(5.9) 6.5 - 7.3 (7.8) × (2) 2.1 - 2.5 (2.6) µm
Q = (2.6) 2.8 - 3.2 (3.4) ; N = 40
Me = 6.9 × 2.3 µm ; Qe = 3
Observaciones: Las medidas esporales del presente estudio se encontrarían por debajo de las indicadas en el trabajo de Ryvarden (7-9 x 2.5-3 μm,), más concordantes con las que se citan en el documento de 2008 de Michal Tomsôvský "Molecular phylogeny and taxonomic position of Trametes cervina and description of a new genus Trametopsis" en el que se citan unas medidas esporales para la Trametopsis cervina de (5.5–)6–7–9(–10) × (1.7–)2–3 μm.
Y mis medidas ya coincidentes a la perfección por las indicadas en el trabajo del genial maestro Enrique Rubio, dejo el enlace:
www.centrodeestudiosmicologicosasturianos.org/?p=25074
Saludos a tod@s.
Un Polyporal quer solo recuerdo haberlo visto una vez allá por 2014, cuando ni tan siquiera había empezado con la microscopía, después de casi 10 años por fin me lo he vuelto a encontrar y he podido confirmar la especie.
Trametopsis cervina (Schwein.) Tomšovský
En el punto de recogida de muestras los ejemplares ya no presentaban ni mucho menos su mejor aspecto, con una consistencia muy parecida a la de la madera, llegué a considerar la posibilidad de que quizás estuvieran ya muertos.
Ya en casa y después de sumergirlos en agua durante un par de horas su aspecto ya cambió considerablemente, con una consistencia bastante blanda y flexible.
Detalle del himenio, con aspecto daedaleoide.
Al depositar el ejemplar sobre la mesa boca abajo, a las dos horas ya había soltado una buena cantidad de esporas, la esporada en masa de color blanco.
Con sistema hifal dimítico, con las hifas generativas provistas de fíbulas,
Las hifas subhimeniales:
Las hifas de la superficie del sombrero (cutícula)
Sin cistidios observados, aunque en la literatura se citan unos pequeños cistidiolos fusoides muy escasos y dispersos.
Los basidios:
Detalle de la base fibulada de los basidios:
Las esporas en solución de Rojo Congo diluido.
Las esporas en agua.
Estas esporas obtenidas por esporulación natural y en agua del grifo con unas medidas de:
(5.9) 6.5 - 7.3 (7.8) × (2) 2.1 - 2.5 (2.6) µm
Q = (2.6) 2.8 - 3.2 (3.4) ; N = 40
Me = 6.9 × 2.3 µm ; Qe = 3
Observaciones: Las medidas esporales del presente estudio se encontrarían por debajo de las indicadas en el trabajo de Ryvarden (7-9 x 2.5-3 μm,), más concordantes con las que se citan en el documento de 2008 de Michal Tomsôvský "Molecular phylogeny and taxonomic position of Trametes cervina and description of a new genus Trametopsis" en el que se citan unas medidas esporales para la Trametopsis cervina de (5.5–)6–7–9(–10) × (1.7–)2–3 μm.
Y mis medidas ya coincidentes a la perfección por las indicadas en el trabajo del genial maestro Enrique Rubio, dejo el enlace:
www.centrodeestudiosmicologicosasturianos.org/?p=25074
Saludos a tod@s.
Adjuntos:
Última Edición: 3 años 1 mes antes por Josep Torres. Razón: Una falta de ortografía
El siguiente usuario dijo gracias: Juan Andrés Román, Juan
Por favor, Identificarse para unirse a la conversación.
- Juan
-

- Fuera de línea
- Moderador
-

Menos
Más
- Mensajes: 553
- Gracias recibidas: 608
3 años 1 mes antes #108691
por Juan
Respuesta de Juan sobre el tema Trametopsis cervina (Schwein.) Tomšovský. Microscopía.
Buenos días Josep... que increíble 10 años!!
Así que esta es la famosa seta que se parece a la ornamenta de los ciervos :O
También es muy utilizada en la medicina tradicional china para enfermedades del hígado y riñones
Así que esta es la famosa seta que se parece a la ornamenta de los ciervos :O
También es muy utilizada en la medicina tradicional china para enfermedades del hígado y riñones
El siguiente usuario dijo gracias: Juan Andrés Román, Josep Torres
Por favor, Identificarse para unirse a la conversación.
- Juan Andrés Román
-

- Fuera de línea
- Spammer
-

Menos
Más
- Mensajes: 2558
- Gracias recibidas: 2756
3 años 1 mes antes #108697
por Juan Andrés Román
Respuesta de Juan Andrés Román sobre el tema Trametopsis cervina (Schwein.) Tomšovský. Microscopía.
El siguiente usuario dijo gracias: Josep Torres, Juan
Por favor, Identificarse para unirse a la conversación.
- Josep Torres
-
 Autor del tema
Autor del tema
- Fuera de línea
- Moderador
-

Menos
Más
- Mensajes: 8746
- Gracias recibidas: 8379
3 años 1 mes antes #108703
por Josep Torres
Respuesta de Josep Torres sobre el tema Trametopsis cervina (Schwein.) Tomšovský. Microscopía.
Muchas gracias a los dos.
Últimamente se están realizando muchos estudios sobre los Poliporales, con resultados bastante alentadores en cuanto a sus cualidades terapéuticas y medicinales, en especial con los del género Ganoderrma.
Un abrazo a los dos.
Últimamente se están realizando muchos estudios sobre los Poliporales, con resultados bastante alentadores en cuanto a sus cualidades terapéuticas y medicinales, en especial con los del género Ganoderrma.
Un abrazo a los dos.
El siguiente usuario dijo gracias: Juan Andrés Román, Juan
Por favor, Identificarse para unirse a la conversación.
- Foro
- Foros sobre Micología de fungipedia
- Microscopía
- Trametopsis cervina (Schwein.) Tomšovský. Microscopía.
Tiempo de carga de la página: 0.190 segundos

Foro de micología